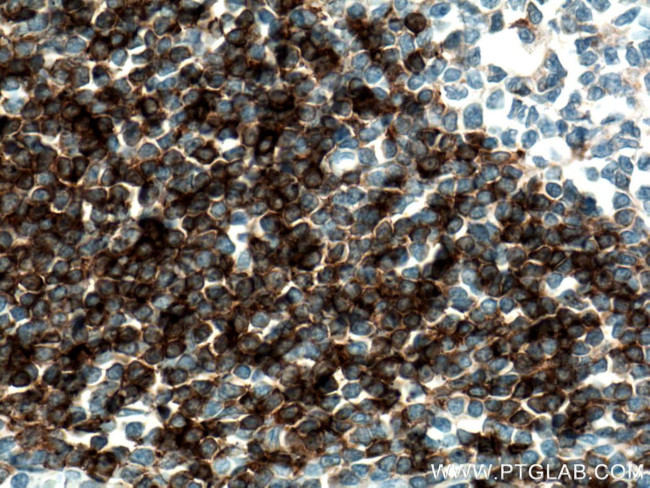
IGHD Antibody in Immunohistochemistry (Paraffin) (IHC (P))

Search
Proteintech
IGHD Polyclonal Antibody
{{$productOrderCtrl.translations['antibody.pdp.commerceCard.promotion.promotions']}}
{{$productOrderCtrl.translations['antibody.pdp.commerceCard.promotion.viewpromo']}}
{{$productOrderCtrl.translations['antibody.pdp.commerceCard.promotion.promocode']}}: {{promo.promoCode}} {{promo.promoTitle}} {{promo.promoDescription}}. {{$productOrderCtrl.translations['antibody.pdp.commerceCard.promotion.learnmore']}}
产品信息
16489-1-AP
种属反应
宿主/亚型
分类
类型
抗原
偶联物
形式
浓度
规格
纯化类型
保存液
内含物
保存条件
运输条件
产品详细信息
This antibody recognize the heavy chain (~60 kDa) of IgD.
Immunogen sequence: RRDSYYMTS SQLSTPLQQW RQGEYKCVVQ HTASKSKKEI FRWPESPKAQ ASSVPTAQPQ AEGSLAKATT APATTRNTGR GGEEKKKEKE KEEQEERETK TPECPSHTQP LGVYLLTPAV QDLWLRDKAT FTCFVVGSDL KDAHLTWEVA GKVPTGGVEE GLLERHSNGS QSQHSRLTLP RSLWNAGTSV TCTLNHPSLP PQRLMALREP AAQAPVKLSL NLLASSDPPE AASWLLCEVS GFSPPNILLM WLEDQREVNT SGFAPARPPP QPGSTTFWAW SVLRVPAPPS PQPATYTCVV SHEDSRTLLN ASRSLEVSYL AMTPLIPQSK DENSDDYTTF DDVGSLWT (202-548 aa encoded by BC021276)
靶标信息
This type I transmembrane protein is co-expressed on the surface of mature naive B cells with membrane IgM. IgD also exists as a soluble form in blood serum. Studies have demonstrated that IgD associates with the B cell receptor and participates in mediating signal transduction upon antigen binding.
仅用于科研。不用于诊断过程。未经明确授权不得转售。
篇参考文献 (0)
生物信息学
蛋白别名: Ig delta chain constant region; IGHD1; IGHDELTA; unnamed protein product
Entrez Gene ID: (Human) 3495